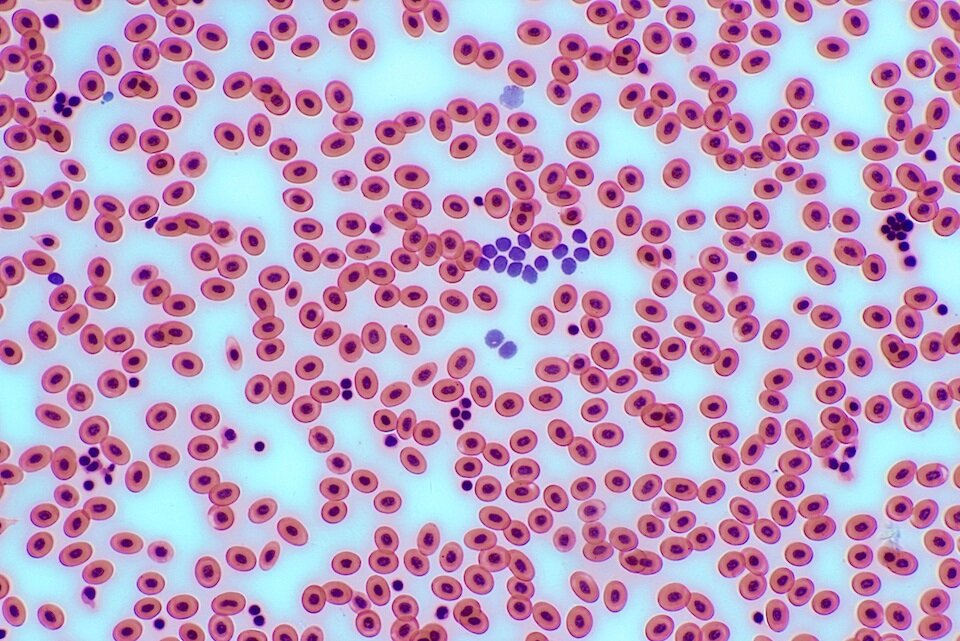
Ilustracja przedstawia wiele komórek o okrągłym kształcie w różowym kolorze. Część z nich jest ze sobą połączona, tworząc łańcuszki. Na ilustracji widać skupiska mniejszych fioletowych komórek.

Non-metal – position in the periodic table and states of matter
what are the properties of matter in different states;
what are symbols of chemical elements and how to use them;
how to determine and distinguish physical and chemical properties;
according to which criteria mixtures are classified;
what safety rules should be followed in the school chemical laboratory.
which non‑metals are contained in human body and what role they play;
which non‑metals are located in the periodic table of elements;
name non‑metals’ states of matter and provide examples;
indicate which elements are allotropes;
distinguish metals and non‑metals based on properties.
What kind non‑metals build a human body?
Living organisms (including the human body) are built of four elements commonly found in the Universe in approx. 96%. Their average weight in a person weighing 50 kg is:
32.5 kg of oxygen,
9.25 kg of carbon,
4.75 kg of hydrogen,
1.6 kg of nitrogen.
The average percentage of elements and selected functions that they perform in the body:
oxygen (65%) – among others it is essential for the brain's functioning, breathing and combustion in cells;
carbon (18%) – the building block of all living cells;
hydrogen (10%) – along with oxygen it forms water, which is 60 - 80% of the body's mass, it is a component of, among others proteins, sugars, fats
nitrogen (3%) – essential in the process of cell structure, a component of proteins;
phosphorus (1%) – similarly to calcium (1.5%) it is a component of compounds from which teeth and bones are made of;
In trace amounts:
sulphur – component of nails and hair;
iodine – necessary for the production of thyroid hormones.

Element | Symbol | Content in the body [%] |
oxygen | O | 65.0 |
carbon | C | 18.0 |
hydrogen | H | 10.0 |
nitrogen | N | 3.0 |
calcium | Ca | 1.5 |
phosphorus | P | 1.0 |
sulphur | S | 0.3 |
sodium | Na | 0.2 |
View the photo gallery and find out what is the role of our so‑called trace elements. Why are they important?
Look for information on the internet about the ions of elements and compounds found in food products Find out what it means for our health and while using available sources of knowledge answer why these are important for the proper functioning of the human body. Write down the answers.
Look for information about other trace elements that are important to humans: chlorine, silicon and sulfur. Write down their role in the body and the dangers posed by their deficiencies. Indicate the sources of these elements in the diet.
Do you think that the use of dietary supplements, e.g. preparations containing chemical compounds with iodine or selenium ions, is justified? In which cases it is and when it is not? Write down the answer.
The position of non‑metals in the periodic table
Currently, 118 chemical elements are known. Recently, 4 of them with atomic numbers 113 (nihonium), 115 (moscovium), 117 (tennessine) and 118 (oganesson) were confirmed in 2015. The left side of the periodic table is occupied by metals, while the right side is occupied by non‑metalsnon‑metals. These elements form an oblique line, with the exception of hydrogen located in the upper left corner. The most well‑known are: sulphur, carbon, oxygen, nitrogen, hydrogen, phosphorus, iodine and chlorine. Some elements may have various forms, e.g. carbon, which occurs in several varieties, including grey‑black graphite and colourless diamond.
What is the state of matter of non‑metals?
Find following elements in the periodic table: oxygen, carbon, sulphur, nitrogen, bromine, chlorine, phosphorus and iodine. Familiarize yourself with their characteristics. View photo gallery below as well and write down information about their states of matter here or in a notebook.
Write down the names of non‑metals from the periodic table:
with the lowest and highest boiling point,
with the largest and the smallest density.
Check if you have correctly memorized the non‑metal state of matter at normal conditions (25°C and 1.0 atm), by clicking on the drop‑down table with the information.
Allotropic types of elements
Some non‑metals occur in nature in several varieties that differ with their internal structure. Such types are called allotropic.
There are known allotropic types of carbon (e.g. diamond, graphite, fullerenes, graphene), sulphur (rhombic and monoclinic) and phosphorus (white, red, violet and black) and oxygen, differing in the number of atoms in the molecule (oxygen , ozone , red oxygen ).

Graphene – the material of the future
The theoretical description of graphene was made in 1947, while in 2010, the Nobel Prize in physics was awarded for its discovery. Graphene is the most durable material in nature – a hundred times more durable than steel. Perfectly conducts heat and electricity. It has a low density, it is thin (composed of one layer of carbon atoms) and transparent. One gram of graphene can cover the surface of several football fields. In Poland, research to obtain high quality graphene lasted since 2006, but in 2013 commercial success was achieved and production started. If we could produce everyday objects from graphene, it would revolutionize our lives more than silicon. There could be stretchable and transparent tablets that can be rolled and put into a pocket, processors several hundred times faster than silicon‑ones or artificial tendons for implantation into joints.

Summary
We divide chemical elements into metals and non‑metals.
Non‑metals form the right part of the periodic table, the exception is hydrogen, which is in the first group.
Non‑metals occur in all states of matter.
Key words
Non‑metals, state of matter, trace elements, allotropes
Glossary
niemetale – pierwiastki chemiczne, które w odróżnieniu od metali źle przewodzą prąd elektryczny (z wyjątkiem grafitu, grafenu i fosforu czarnego) i ciepło (z wyjątkiem diamentu, grafitu i fosforu czarnego); w stanie stałym są na ogół kruche, bez metalicznego połysku (z wyjątkiem jodu, krzemu, grafitu)